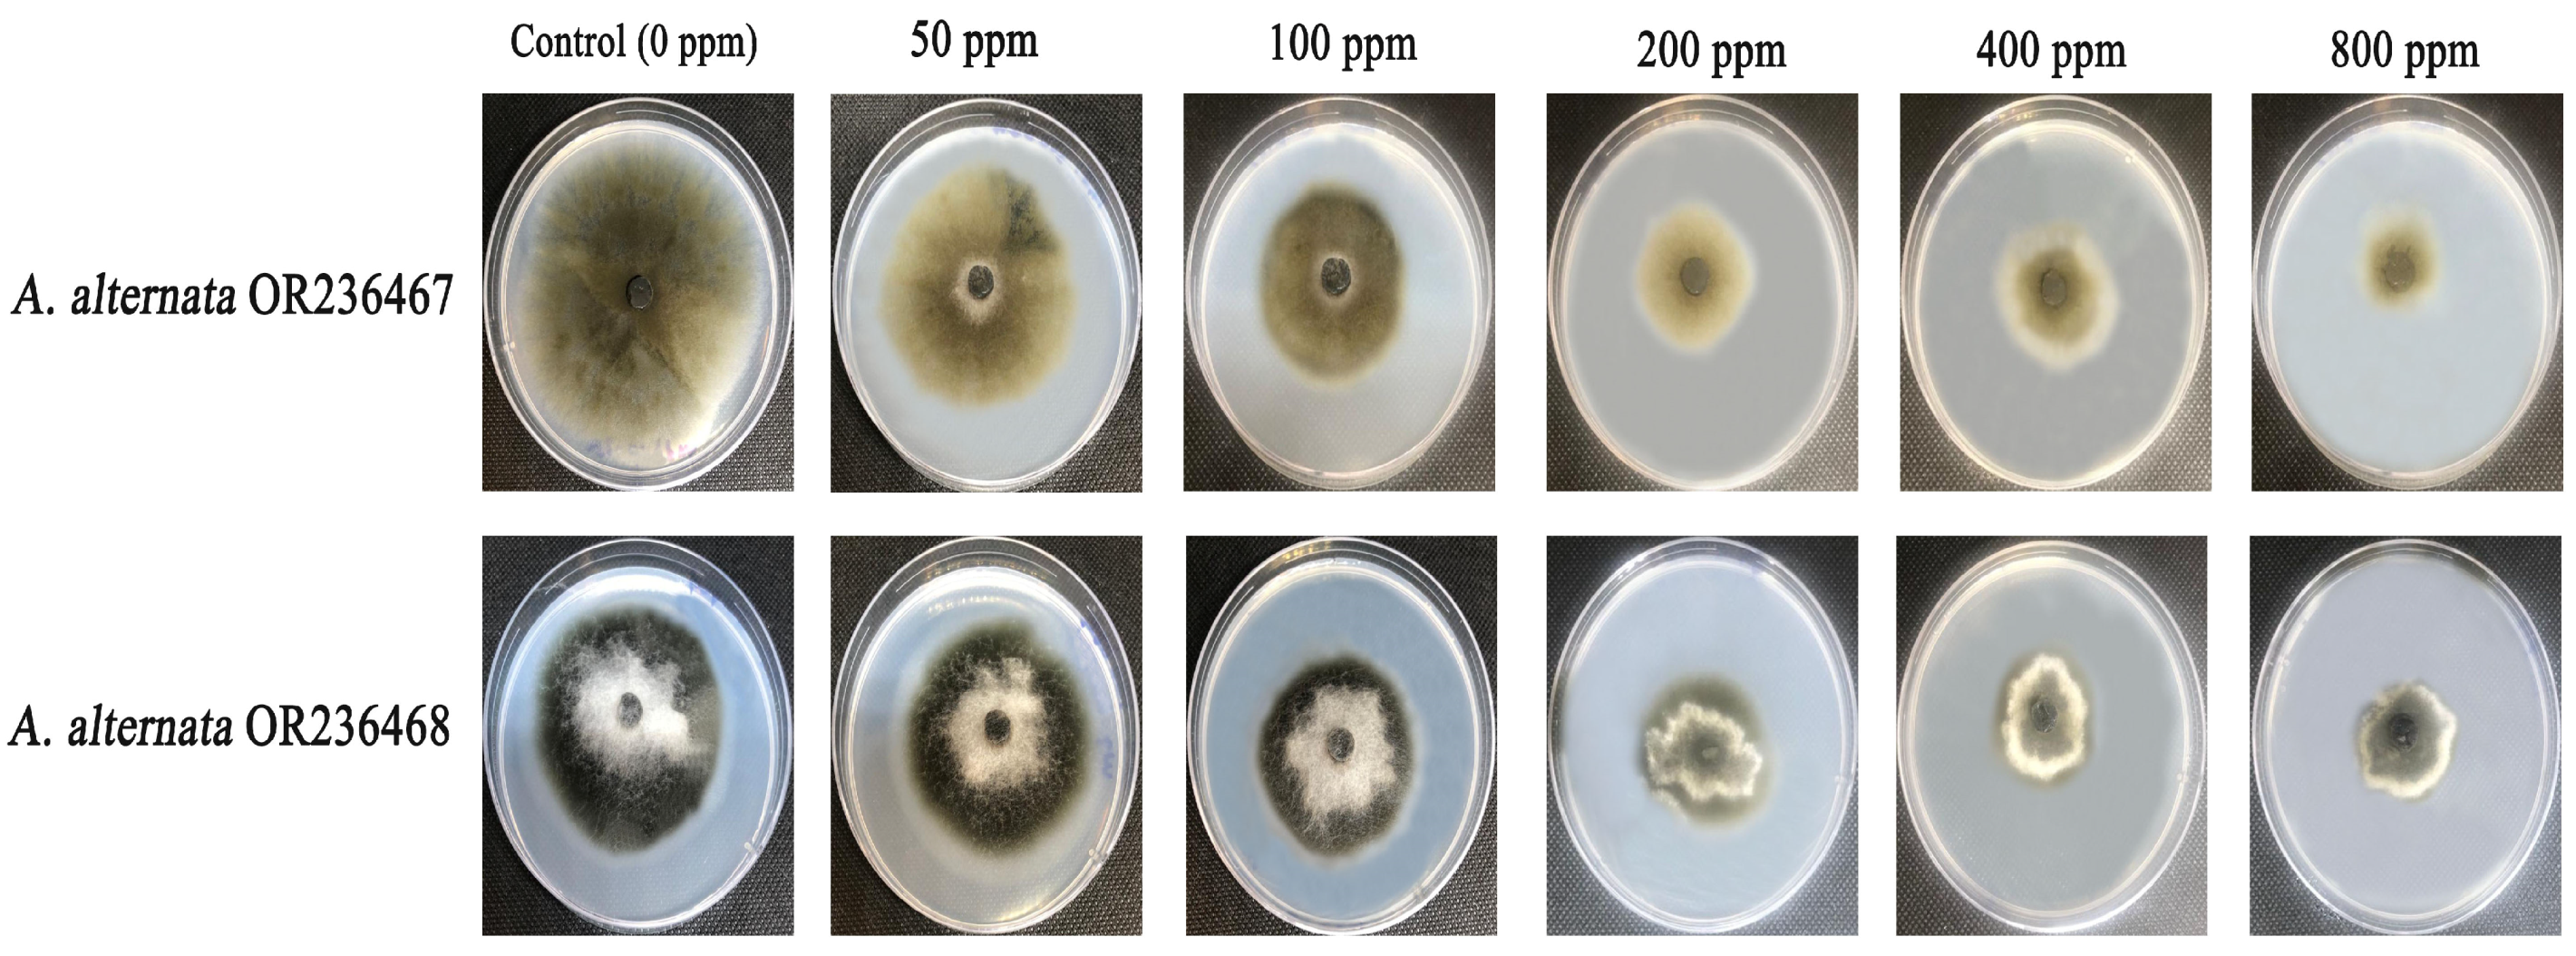
Applsci 13 09942 g011

Green Synthesis, Characterization, and Antifungal Efficiency of Biogenic Iron Oxide Nanoparticles
Abstract
:1. Introduction
2. Materials and Methods
2.1. Preparation of L. nobilis Extract
2.2. Green Biofabrication of IONPs
2.3. Physicochemical Characterization of the Biogenic IONPs
2.4. Antifungal Efficiency of Standard Fungicide against the Tested Strains
2.5. Antifungal Effectiveness of the Biogenic IONPs against the Tested Fungal Strain
2.6. Antioxidant Assay
2.7. Statistical Analysis
3. Results and Discussion
3.1. Green Biosynthesis of IONPs
3.2. UV Analysis of the Phyto-Synthesized IONPs
3.3. EDX Analysis of the Biogenic IONPs
3.4. FTIR Analysis of the Biogenic Fe2O3 Nanoparticles
3.5. TEM Investigation of IONPs
3.6. XRD Analysis of the Biogenic IONPs
3.7. Zeta Potential Analysis
3.8. Antifungal Efficacy of Standard Fungicide and Biogenic Iron Oxide Nanoparticles Against
3.9. Antioxidant Activity
4. Conclusions
Author Contributions
Funding
Institutional Review Board Statement
Informed Consent Statement
Data Availability Statement
Acknowledgments
Conflicts of Interest
References
- Dukare, A.S.; Paul, S.; Nambi, V.E.; Gupta, R.K.; Singh, R.; Sharma, K.; Vishwakarma, R.K. Exploitation of Microbial Antagonists for the Control of Postharvest Diseases of Fruits: A Review. Crit. Rev. Food Sci. Nutr. 2019, 59, 1498–1513. [Google Scholar] [CrossRef]
- Carmona-Hernandez, S.; Reyes-Pérez, J.J.; Chiquito-Contreras, R.G.; Rincon-Enriquez, G.; Cerdan-Cabrera, C.R.; Hernandez-Montiel, L.G. Biocontrol of Postharvest Fruit Fungal Diseases by Bacterial Antagonists: A Review. Agronomy 2019, 9, 121. [Google Scholar] [CrossRef]
- Fisher, M.C.; Henk, D.A.; Briggs, C.J.; Brownstein, J.S.; Madoff, L.C.; McCraw, S.L.; Gurr, S.J. Emerging Fungal Threats to Animal, Plant and Ecosystem Health. Nature 2012, 484, 186–194. [Google Scholar] [CrossRef]
- Benedict, K.; Chiller, T.M.; Mody, R.K. Invasive Fungal Infections Acquired from Contaminated Food or Nutritional Supplements: A Review of the Literature. Foodborne Pathog. Dis. 2016, 13, 343–349. [Google Scholar] [CrossRef]
- Leyva Salas, M.; Mounier, J.; Valence, F.; Coton, M.; Thierry, A.; Coton, E. Antifungal Microbial Agents for Food Biopreservation—A Review. Microorganisms 2017, 5, 37. [Google Scholar] [CrossRef] [PubMed]
- Yuan, S.; Yan, J.; Wang, M.; Ding, X.; Zhang, Y.; Li, W.; Cao, J.; Jiang, W. Transcriptomic and Metabolic Profiling Reveals ‘Green Ring’ and ‘Red Ring’ on Jujube Fruit upon Postharvest Alternaria Alternata Infection. Plant Cell Physiol. 2019, 60, 844–861. [Google Scholar] [CrossRef] [PubMed]
- Guo, W.; Fan, K.; Nie, D.; Meng, J.; Huang, Q.; Yang, J.; Shen, Y.; Tangni, E.K.; Zhao, Z.; Wu, Y.; et al. Development of a QuEChERS-Based UHPLC-MS/MS Method for Simultaneous Determination of Six Alternaria Toxins in Grapes. Toxins 2019, 11, 87. [Google Scholar] [CrossRef]
- Shu, C.; Zhao, H.; Jiao, W.; Liu, B.; Cao, J.; Jiang, W. Antifungal Efficacy of Ursolic Acid in Control of Alternaria Alternata Causing Black Spot Rot on Apple Fruit and Possible Mechanisms Involved. Sci. Hortic. 2019, 256, 108636. [Google Scholar] [CrossRef]
- Saha, D.; Fetzner, R.; Burkhardt, B.; Podlech, J.; Metzler, M.; Dang, H.; Lawrence, C.; Fischer, R. Identification of a Polyketide Synthase Required for Alternariol (AOH) and Alternariol-9-Methyl Ether (AME) Formation in Alternaria Alternata. PLoS ONE 2012, 7, e40564. [Google Scholar] [CrossRef]
- Liu, Y.; Wang, Y.; Ma, L.; Fu, R.; Liu, H.; Cui, Y.; Zhao, Q.; Zhang, Y.; Jiao, B.; He, Y. A CRISPR/Cas12a-Based Photothermal Platform for the Portable Detection of Citrus-Associated Alternaria Genes Using a Thermometer. Int. J. Biol. Macromol. 2022, 222, 2661–2669. [Google Scholar] [CrossRef]
- Shtienberg, D. Effects of Host Physiology on the Development of Core Rot, Caused by Alternaria Alternata, in Red Delicious Apples. Phytopathology 2012, 102, 769–778. [Google Scholar] [CrossRef]
- Bai, Y.; Feng, Z.; Paerhati, M.; Wang, J. Phenylpropanoid Metabolism Enzyme Activities and Gene Expression in Postharvest Melons Inoculated with Alternaria Alternata. Appl. Biol. Chem. 2021, 64, 83. [Google Scholar] [CrossRef]
- Castro, J.C.; Endo, E.H.; de Souza, M.R.; Zanqueta, E.B.; Polonio, J.C.; Pamphile, J.A.; Ueda-Nakamura, T.; Nakamura, C.V.; Dias Filho, B.P.; de Abreu Filho, B.A. Bioactivity of Essential Oils in the Control of Alternaria Alternata in Dragon Fruit (Hylocereus Undatus Haw.). Ind. Crops Prod. 2017, 97, 101–109. [Google Scholar] [CrossRef]
- Wenneker, M.; Thomma, B.P.H.J. Latent Postharvest Pathogens of Pome Fruit and Their Management: From Single Measures to a Systems Intervention Approach. Eur. J. Plant Pathol. 2020, 156, 663–681. [Google Scholar] [CrossRef]
- Rafiq, S.; Kaul, R.; Sofi, S.A.; Bashir, N.; Nazir, F.; Ahmad Nayik, G. Citrus Peel as a Source of Functional Ingredient: A Review. J. Saudi Soc. Agric. Sci. 2018, 17, 351–358. [Google Scholar] [CrossRef]
- Zaller, J.G.; Brühl, C.A. Editorial: Non-Target Effects of Pesticides on Organisms Inhabiting Agroecosystems. Front. Environ. Sci. 2019, 7, 75. [Google Scholar]
- Kanwar, V.S.; Sharma, A.; Srivastav, A.L.; Rani, L. Phytoremediation of Toxic Metals Present in Soil and Water Environment: A Critical Review. Environ. Sci. Pollut. Res. 2020, 27, 44835–44860. [Google Scholar] [CrossRef]
- Rani, L.; Thapa, K.; Kanojia, N.; Sharma, N.; Singh, S.; Grewal, A.S.; Srivastav, A.L.; Kaushal, J. An Extensive Review on the Consequences of Chemical Pesticides on Human Health and Environment. J. Clean. Prod. 2021, 283, 124657. [Google Scholar] [CrossRef]
- Gikas, G.D.; Parlakidis, P.; Mavropoulos, T.; Vryzas, Z. Particularities of Fungicides and Factors Affecting Their Fate and Removal Efficacy: A Review. Sustainability 2022, 14, 4056. [Google Scholar] [CrossRef]
- Moraes Bazioli, J.; Belinato, J.R.; Costa, J.H.; Akiyama, D.Y.; Pontes, J.G.d.M.; Kupper, K.C.; Augusto, F.; de Carvalho, J.E.; Fill, T.P. Biological Control of Citrus Postharvest Phytopathogens. Toxins 2019, 11, 460. [Google Scholar] [CrossRef]
- Santamarina, M.; Ibáñez, M.; Marqués, M.; Roselló, J.; Giménez, S.; Blázquez, M. Bioactivity of Essential Oils in Phytopathogenic and Post-Harvest Fungi Control. Nat. Prod. Res. 2017, 31, 2675–2679. [Google Scholar] [CrossRef]
- Elmer, W.; Ma, C.; White, J. Nanoparticles for Plant Disease Management. Curr. Opin. Environ. Sci. Health 2018, 6, 66–70. [Google Scholar] [CrossRef]
- Singh, R.P.; Handa, R.; Manchanda, G. Nanoparticles in Sustainable Agriculture: An Emerging Opportunity. J. Control. Release 2021, 329, 1234–1248. [Google Scholar] [CrossRef]
- Bandala, E.R.; Berli, M. Engineered Nanomaterials (ENMs) and Their Role at the Nexus of Food, Energy, and Water. Mater. Sci. Energy Technol. 2019, 2, 29–40. [Google Scholar] [CrossRef]
- Ashraf, S.A.; Siddiqui, A.J.; Elkhalifa, A.E.O.; Khan, M.I.; Patel, M.; Alreshidi, M.; Moin, A.; Singh, R.; Snoussi, M.; Adnan, M. Innovations in Nanoscience for the Sustainable Development of Food and Agriculture with Implications on Health and Environment. Sci. Total Environ. 2021, 768, 144990. [Google Scholar] [CrossRef]
- Zaytseva, O.; Neumann, G. Carbon Nanomaterials: Production, Impact on Plant Development, Agricultural and Environmental Applications. Chem. Biol. Technol. Agric. 2016, 3, 17. [Google Scholar] [CrossRef]
- Vinzant, K.; Rashid, M.; Khodakovskaya, M.V. Advanced Applications of Sustainable and Biological Nano-Polymers in Agricultural Production. Front. Plant Sci. 2023, 13, 1081165. [Google Scholar] [PubMed]
- El-Beltagi, H.S.; Bendary, E.S.; Ramadan, K.M.A.; Mohamed, H.I. Metallic Nanoparticles and Nano-Based Bioactive Formulations as Nano-Fungicides for Sustainable Disease Management in Cereals. In Cereal Diseases: Nanobiotechnological Approaches for Diagnosis and Management; Abd-Elsalam, K.A., Mohamed, H.I., Eds.; Springer Nature: Singapore, 2022; pp. 315–343. ISBN 978-981-19312-0-8. [Google Scholar]
- Tesser, M.E.; Guilger, M.; Bilesky-José, N.; Risso, W.E.; de Lima, R.; dos Reis Martinez, C.B. Biogenic Metallic Nanoparticles (Ag, TiO2, Fe) as Potential Fungicides for Agriculture: Are They Safe for the Freshwater Mussel Anodontites Trapesialis? Chemosphere 2022, 309, 136664. [Google Scholar] [CrossRef] [PubMed]
- Ul Haq, I.; Ijaz, S. Use of Metallic Nanoparticles and Nanoformulations as Nanofungicides for Sustainable Disease Management in Plants. In Nanobiotechnology in Bioformulations; Prasad, R., Kumar, V., Kumar, M., Choudhary, D., Eds.; Nanotechnology in the Life Sciences; Springer International Publishing: Cham, Switzerland, 2019; pp. 289–316. ISBN 978-3-030-17061-5. [Google Scholar]
- Hernández-Díaz, J.A.; Garza-García, J.J.; Zamudio-Ojeda, A.; León-Morales, J.M.; López-Velázquez, J.C.; García-Morales, S. Plant-Mediated Synthesis of Nanoparticles and Their Antimicrobial Activity against Phytopathogens. J. Sci. Food Agric. 2021, 101, 1270–1287. [Google Scholar] [CrossRef] [PubMed]
- Maity, D.; Gupta, U.; Saha, S. Biosynthesized Metal Oxide Nanoparticles for Sustainable Agriculture: Next-Generation Nanotechnology for Crop Production, Protection and Management. Nanoscale 2022, 14, 13950–13989. [Google Scholar] [CrossRef]
- Bilal, M.; Iqbal, H.M.N.; Adil, S.F.; Shaik, M.R.; Abdelgawad, A.; Hatshan, M.R.; Khan, M. Surface-Coated Magnetic Nanostructured Materials for Robust Bio-Catalysis and Biomedical Applications—A Review. J. Adv. Res. 2022, 38, 157–177. [Google Scholar] [CrossRef]
- Abdelhamid, H.N.; Wu, H.-F. Multifunctional Graphene Magnetic Nanosheet Decorated with Chitosan for Highly Sensitive Detection of Pathogenic Bacteria. J. Mater. Chem. B 2013, 1, 3950. [Google Scholar] [CrossRef]
- Gopal, J.; Abdelhamid, H.N.; Hua, P.-Y.; Wu, H.-F. Chitosan Nanomagnets for Effective Extraction and Sensitive Mass Spectrometric Detection of Pathogenic Bacterial Endotoxin from Human Urine. J. Mater. Chem. B 2013, 1, 2463–2475. [Google Scholar] [CrossRef]
- Tartaj, P.; Morales, M.P.; González-Carreño, T.; Veintemillas-Verdaguer, S.; Serna, C.J. Advances in Magnetic Nanoparticles for Biotechnology Applications. J. Magn. Magn. Mater. 2005, 290–291, 28–34. [Google Scholar] [CrossRef]
- Wani, A.H.; Amin, M.; Shahnaz, M.; Shah, M.A. Antimycotic Activity of Nanoparticles of MgO, FeO and ZnO on Some Pathogenic Fungi. Int. J. Manuf. Mater. Mech. Eng. 2012, 2, 59–70. [Google Scholar] [CrossRef]
- Bilesky-José, N.; Maruyama, C.; Germano-Costa, T.; Campos, E.; Carvalho, L.; Grillo, R.; Fraceto, L.F.; de Lima, R. Biogenic α-Fe2O3 Nanoparticles Enhance the Biological Activity of Trichoderma against the Plant Pathogen Sclerotinia Sclerotiorum. ACS Sustain. Chem. Eng. 2021, 9, 1669–1683. [Google Scholar] [CrossRef]
- Henam, S.D.; Ahmad, F.; Shah, M.A.; Parveen, S.; Wani, A.H. Microwave Synthesis of Nanoparticles and Their Antifungal Activities. Spectrochim. Acta. A. Mol. Biomol. Spectrosc. 2019, 213, 337–341. [Google Scholar] [CrossRef]
- Bharathi, D.; Preethi, S.; Abarna, K.; Nithyasri, M.; Kishore, P.; Deepika, K. Bio-Inspired Synthesis of Flower Shaped Iron Oxide Nanoparticles (FeONPs) Using Phytochemicals of Solanum Lycopersicum Leaf Extract for Biomedical Applications. Biocatal. Agric. Biotechnol. 2020, 27, 101698. [Google Scholar] [CrossRef]
- Mirza, A.U.; Kareem, A.; Nami, S.A.A.; Khan, M.S.; Rehman, S.; Bhat, S.A.; Mohammad, A.; Nishat, N. Biogenic Synthesis of Iron Oxide Nanoparticles Using Agrewia Optiva and Prunus Persica Phyto Species: Characterization, Antibacterial and Antioxidant Activity. J. Photochem. Photobiol. B 2018, 185, 262–274. [Google Scholar] [CrossRef]
- Falade, A.O.; Adewole, K.E.; Adekola, A.-R.O.; Ikokoh, H.A.; Okaiyeto, K.; Oguntibeju, O.O. Aqueous Extract of Bay Leaf (Laurus Nobilis) Ameliorates Testicular Toxicity Induced by Aluminum Chloride in Rats. Vet. World 2022, 15, 2525. [Google Scholar] [CrossRef]
- Afzal, S.; Sharma, D.; Singh, N.K. Eco-Friendly Synthesis of Phytochemical-Capped Iron Oxide Nanoparticles as Nano-Priming Agent for Boosting Seed Germination in Rice (Oryza sativa L.). Environ. Sci. Pollut. Res. 2021, 28, 40275–40287. [Google Scholar] [CrossRef]
- Groiss, S.; Selvaraj, R.; Varadavenkatesan, T.; Vinayagam, R. Structural Characterization, Antibacterial and Catalytic Effect of Iron Oxide Nanoparticles Synthesised Using the Leaf Extract of Cynometra Ramiflora. J. Mol. Struct. 2017, 1128, 572–578. [Google Scholar] [CrossRef]
- Jagathesan, G.; Rajiv, P. Biosynthesis and Characterization of Iron Oxide Nanoparticles Using Eichhornia Crassipes Leaf Extract and Assessing Their Antibacterial Activity. Biocatal. Agric. Biotechnol. 2018, 13, 90–94. [Google Scholar] [CrossRef]
- Braim, F.S.; Nik Ab Razak, N.N.A.; Aziz, A.A.; Dheyab, M.A.; Ismael, L.Q. Rapid Green-Assisted Synthesis and Functionalization of Superparamagnetic Magnetite Nanoparticles Using Sumac Extract and Assessment of Their Cellular Toxicity, Uptake, and Anti-Metastasis Property. Ceram. Int. 2023, 49, 7359–7369. [Google Scholar] [CrossRef]
- Periakaruppan, R.; Chen, X.; Thangaraj, K.; Jeyaraj, A.; Nguyen, H.H.; Yu, Y.; Hu, S.; Lu, L.; Li, X. Utilization of Tea Resources with the Production of Superparamagnetic Biogenic Iron Oxide Nanoparticles and an Assessment of Their Antioxidant Activities. J. Clean. Prod. 2021, 278, 123962. [Google Scholar] [CrossRef]
- Hoffmann, N.; Tortella, G.; Hermosilla, E.; Fincheira, P.; Diez, M.C.; Lourenço, I.M.; Seabra, A.B.; Rubilar, O. Comparative Toxicity Assessment of Eco-Friendly Synthesized Superparamagnetic Iron Oxide Nanoparticles (SPIONs) in Plants and Aquatic Model Organisms. Minerals 2022, 12, 451. [Google Scholar] [CrossRef]
- Alghuthaymi, M.A.; Rajkuberan, C.; Santhiya, T.; Krejcar, O.; Kuča, K.; Periakaruppan, R.; Prabukumar, S. Green Synthesis of Gold Nanoparticles Using Polianthes Tuberosa L. Floral Extract. Plants 2021, 10, 2370. [Google Scholar] [CrossRef] [PubMed]
- Selim, Y.A.; Azb, M.A.; Ragab, I.; HM Abd El-Azim, M. Green Synthesis of Zinc Oxide Nanoparticles Using Aqueous Extract of Deverra Tortuosa and Their Cytotoxic Activities. Sci. Rep. 2020, 10, 3445. [Google Scholar] [CrossRef] [PubMed]
- Shehzad, A.; Qureshi, M.; Jabeen, S.; Ahmad, R.; Alabdalall, A.H.; Aljafary, M.A.; Al-Suhaimi, E. Synthesis, Characterization and Antibacterial Activity of Silver Nanoparticles Using Rhazya Stricta. PeerJ 2018, 6, e6086. [Google Scholar] [CrossRef] [PubMed]
- Nagaonkar, D.; Gaikwad, S.; Rai, M. Catharanthus Roseus Leaf Extract-Synthesized Chitosan Nanoparticles for Controlled in Vitro Release of Chloramphenicol and Ketoconazole. Colloid Polym. Sci. 2015, 293, 1465–1473. [Google Scholar] [CrossRef]
- Umashankari, J.; Inbakandan, D.; Ajithkumar, T.T.; Balasubramanian, T. Mangrove Plant, Rhizophora Mucronata (Lamk, 1804) Mediated One Pot Green Synthesis of Silver Nanoparticles and Its Antibacterial Activity against Aquatic Pathogens. Aquat. Biosyst. 2012, 8, 11. [Google Scholar] [CrossRef] [PubMed]
- Vijayan, R.; Joseph, S.; Mathew, B. Green Synthesis of Silver Nanoparticles Using Nervalia Zeylanica Leaf Extract and Evaluation of Their Antioxidant, Catalytic, and Antimicrobial Potentials. Part. Sci. Technol. 2019, 37, 809–819. [Google Scholar] [CrossRef]
- Chakraborty, A.; Sarangapany, S.; Mishra, U.; Mohanty, K. Green Synthesized Magnetically Separable Iron Oxide Nanoparticles for Efficient Heterogeneous Photo-Fenton Degradation of Dye Pollutants. J. Clust. Sci. 2022, 33, 675–685. [Google Scholar] [CrossRef]
- Sharmila, G.; Thirumarimurugan, M.; Muthukumaran, C. Green Synthesis of ZnO Nanoparticles Using Tecoma Castanifolia Leaf Extract: Characterization and Evaluation of Its Antioxidant, Bactericidal and Anticancer Activities. Microchem. J. 2019, 145, 578–587. [Google Scholar] [CrossRef]
- Donga, S.; Bhadu, G.R.; Chanda, S. Antimicrobial, Antioxidant and Anticancer Activities of Gold Nanoparticles Green Synthesized Using Mangifera Indica Seed Aqueous Extract. Artif. Cells Nanomed. Biotechnol. 2020, 48, 1315–1325. [Google Scholar] [CrossRef]
- Demirezen, D.A.; Yılmaz, Ş.; Yılmaz, D.D.; Yıldız, Y.Ş. Green Synthesis of Iron Oxide Nanoparticles Using Ceratonia Siliqua L. Aqueous Extract: Improvement of Colloidal Stability by Optimizing Synthesis Parameters, and Evaluation of Antibacterial Activity against Gram-Positive and Gram-Negative Bacteria. Int. J. Mater. Res. 2022, 113, 849–861. [Google Scholar] [CrossRef]
- Ilmetov, R. Photocatalytic Activity of Hematite Nanoparticles Prepared by Sol-Gel Method. Mater. Today Proc. 2019, 6, 11–14. [Google Scholar] [CrossRef]
- Rajendran, K.; Karunagaran, V.; Mahanty, B.; Sen, S. Biosynthesis of Hematite Nanoparticles and Its Cytotoxic Effect on HepG2 Cancer Cells. Int. J. Biol. Macromol. 2015, 74, 376–381. [Google Scholar] [CrossRef]
- Joshi, D.P.; Pant, G.; Arora, N.; Nainwal, S. Effect of Solvents on Morphology, Magnetic and Dielectric Properties of (α-Fe2O3 @SiO2) Core-Shell Nanoparticles. Heliyon 2017, 3, e00253. [Google Scholar] [CrossRef] [PubMed]
- Alikord, M.; Shariatifar, N.; Saraji, M.; Jahed Khaniki, G.; Hosseini, H.; Fazeli, M. Biosynthesis of Zinc Oxide Nanoparticles Using Fermented Table Olive Extract: A Novel and Green Approach with Potential Applications. BioNanoScience 2023, 13, 1036–1051. [Google Scholar] [CrossRef]
- Iqbal, J.; Abbasi, B.A.; Ahmad, R.; Shahbaz, A.; Zahra, S.A.; Kanwal, S.; Munir, A.; Rabbani, A.; Mahmood, T. Biogenic Synthesis of Green and Cost Effective Iron Nanoparticles and Evaluation of Their Potential Biomedical Properties. J. Mol. Struct. 2020, 1199, 126979. [Google Scholar] [CrossRef]
- Haris, M.; Fatima, N.; Iqbal, J.; Chalgham, W.; Mumtaz, A.S.; El-Sheikh, M.A.; Tavafoghi, M. Oscillatoria limnetica Mediated Green Synthesis of Iron Oxide (Fe2O3) Nanoparticles and Their Diverse In Vitro Bioactivities. Molecules 2023, 28, 2091. [Google Scholar] [CrossRef] [PubMed]
- Periakaruppan, R.; Kumar, T.S.; Vanathi, P.; Al-Awsi, G.R.L.; Al-Dayan, N.; Dhanasekaran, S. Phyto-Synthesis and Characterization of Parthenium-Mediated Iron Oxide Nanoparticles and an Evaluation of Their Antifungal and Antioxidant Activities and Effect on Seed Germination. JOM 2023, 1–8. [Google Scholar] [CrossRef]
- Win, T.T.; Khan, S.; Bo, B.; Zada, S.; Fu, P. Green Synthesis and Characterization of Fe3O4 Nanoparticles Using Chlorella-K01 Extract for Potential Enhancement of Plant Growth Stimulating and Antifungal Activity. Sci. Rep. 2021, 11, 21996. [Google Scholar] [CrossRef]
- Jamzad, M.; Kamari Bidkorpeh, M. Green Synthesis of Iron Oxide Nanoparticles by the Aqueous Extract of Laurus Nobilis L. Leaves and Evaluation of the Antimicrobial Activity. J. Nanostructure Chem. 2020, 10, 193–201. [Google Scholar] [CrossRef]
- Ahmad, W.; Kumar Jaiswal, K.; Amjad, M. Euphorbia Herita Leaf Extract as a Reducing Agent in a Facile Green Synthesis of Iron Oxide Nanoparticles and Antimicrobial Activity Evaluation. Inorg. Nano-Met. Chem. 2021, 51, 1147–1154. [Google Scholar] [CrossRef]
- Cruz-Luna, A.R.; Cruz-Martínez, H.; Vásquez-López, A.; Medina, D.I. Metal Nanoparticles as Novel Antifungal Agents for Sustainable Agriculture: Current Advances and Future Directions. J. Fungi 2021, 7, 1033. [Google Scholar] [CrossRef] [PubMed]
- Malandrakis, A.A.; Kavroulakis, N.; Chrysikopoulos, C.V. Metal Nanoparticles against Fungicide Resistance: Alternatives or Partners? Pest Manag. Sci. 2022, 78, 3953–3956. [Google Scholar] [CrossRef] [PubMed]
- Cruz-Luna, A.R.; Vásquez-López, A.; Rojas-Chávez, H.; Valdés-Madrigal, M.A.; Cruz-Martínez, H.; Medina, D.I. Engineered Metal Oxide Nanoparticles as Fungicides for Plant Disease Control. Plants 2023, 12, 2461. [Google Scholar] [CrossRef] [PubMed]
- Alam, T.; Akbar, F.; Ali, M.; Munis, M.F.H.; Khan, J. Biosynthesis of iron oxide nanoparticles via crocus sativus and their antifungal efficacy against verticillium wilt pathogen verticillium dahliae. BioRxiv 2019, 861401. [Google Scholar] [CrossRef]
- Singh, K.; Chopra, D.S.; Singh, D.; Singh, N. Optimization and Ecofriendly Synthesis of Iron Oxide Nanoparticles as Potential Antioxidant. Arab. J. Chem. 2020, 13, 9034–9046. [Google Scholar] [CrossRef]

| Functional Groups of the Aqueous Leaf Extract of L. nobilis | ||||
|---|---|---|---|---|
| No. | Absorption Peak (cm−1) | Appearance | Functional Groups | Molecular Motion |
| 1 | 3427.08 | Strong, broad | Phenols | O-H stretching |
| 2 | 2927.22 | Medium | Alkanes | C-H stretching |
| 3 | 2847.61 | Medium | Alkanes | C-H stretching |
| 4 | 1632.01 | Medium | Amines | N-H bending |
| 5 | 1030.37 | Medium | Carbonyl groups | C-O stretching |
| 6 | 540.36 | Weak, broad | Alkyl halides | C-Br stretching |
| Functional groups of the biogenic IONPs | ||||
| 1 | 3434.74 | Strong, broad | Phenols | O-H stretching |
| 2 | 2921.47 | Medium | Alkanes | C-H stretching |
| 3 | 1621.34 | Medium | Amines | N-H bending |
| 4 | 1444.05 | Medium | Aromatic compounds | C-C stretching |
| 5 | 1352.94 | Medium | Phenols | O-H bending |
| 6 | 1176.47 | Medium | Amines | C-N stretching |
| 7 | 1075.45 | Medium | Primary alcohols | C-O stretching |
| 8 | 574.83 | Weak, broad | Alkyl halides | C-Br stretching |
| Fungicide Metalaxyl + Mancozeb (ppm) | Fungal Growth Diameter (mm) | Growth Inhibition Percentage (%) | ||
|---|---|---|---|---|
| A. alternata OR236467 | A. alternata OR236468 | OR236467 | OR236468 | |
| Control (0 ppm) | 78.67 ± 0.11 a | 58.63 ± 0.43 a | 0.00 a | 0.00 a |
| 50 | 67.23 ± 0.54 b | 54.14 ± 0.32 b | 14.54 b | 7.65 b |
| 100 | 58.16 ± 0.42 c | 46.53 ± 0.29 c | 26.07 c | 20.64 c |
| 200 | 43.17 ± 0.61 d | 38.12 ± 0.49 d | 45.13 d | 34.98 d |
| 400 | 30.64 ± 0.17 e | 30.48 ± 0.15 e | 61.05 e | 48.01 e |
| 800 | 21.85 ± 0.31 f | 24.31 ± 0.18 f | 72.23 f | 58.54 f |
| IONPs (ppm) | Fungal Growth Diameter (mm) | Growth Inhibition Percentage (%) | ||
|---|---|---|---|---|
| A. alternata OR236467 | A. alternata OR236468 | OR236467 | OR236468 | |
| Control (0 ppm) | 78.35 ± 0.16 a | 58.14 ± 0.29 a | 0.00 a | 0.00 a |
| 50 | 55.17 ± 0.52 b | 56.87 ± 0.58 a | 29.58 a | 2.18 b |
| 100 | 41.34 ± 0.67 c | 44.97 ± 0.41 b | 47.24 b | 22.65 c |
| 200 | 34.51 ± 0.43 d | 35.55 ± 0.22 c | 55.95 c | 38.85 d |
| 400 | 26.84 ± 0.53 e | 28.91 ± 0.34 d | 65.74 d | 50.28 e |
| 800 | 18.89 ± 0.78 f | 22.89 ± 0.78 e | 75.89 e | 60.63 f |
Disclaimer/Publisher’s Note: The statements, opinions and data contained in all publications are solely those of the individual author(s) and contributor(s) and not of MDPI and/or the editor(s). MDPI and/or the editor(s) disclaim responsibility for any injury to people or property resulting from any ideas, methods, instructions or products referred to in the content. |
© 2023 by the authors. Licensee MDPI, Basel, Switzerland. This article is an open access article distributed under the terms and conditions of the Creative Commons Attribution (CC BY) license (https://creativecommons.org/licenses/by/4.0/).
Share and Cite
Yassin, M.T.; Al-Otibi, F.O.; Al-Askar, A.A.; Alharbi, R.I. Green Synthesis, Characterization, and Antifungal Efficiency of Biogenic Iron Oxide Nanoparticles. Appl. Sci. 2023, 13, 9942. https://doi.org/10.3390/app13179942
Yassin MT, Al-Otibi FO, Al-Askar AA, Alharbi RI. Green Synthesis, Characterization, and Antifungal Efficiency of Biogenic Iron Oxide Nanoparticles. Applied Sciences. 2023; 13(17):9942. https://doi.org/10.3390/app13179942
Chicago/Turabian StyleYassin, Mohamed Taha, Fatimah O. Al-Otibi, Abdulaziz A. Al-Askar, and Raedah Ibrahim Alharbi. 2023. "Green Synthesis, Characterization, and Antifungal Efficiency of Biogenic Iron Oxide Nanoparticles" Applied Sciences 13, no. 17: 9942. https://doi.org/10.3390/app13179942
APA StyleYassin, M. T., Al-Otibi, F. O., Al-Askar, A. A., & Alharbi, R. I. (2023). Green Synthesis, Characterization, and Antifungal Efficiency of Biogenic Iron Oxide Nanoparticles. Applied Sciences, 13(17), 9942. https://doi.org/10.3390/app13179942

